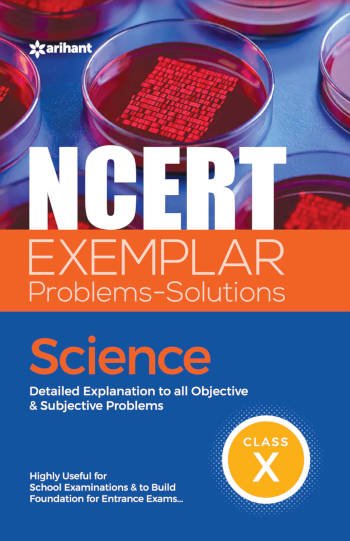
Arihant NCERT Exemplar Problems-Solutions Science Class 10

Description
Get your hands on the latest edition of “NCERT EXEMPLAR PROBLEMS-SOLUTIONS: SCIENCE” which has been designed for class X students to master the basic technique of problem-solving. This book contains Explanatory & Accurate Solutions to all the questions given in the NCERT Exemplar Science book. Besides this, two additional features, that is, Thinking Process and Note have been included to enhance the learning and thinking abilities of students. Acquiring this book will be highly useful to score best in school examinations and build foundation for entrance examinations. It offers:

Reviews
There are no reviews yet.